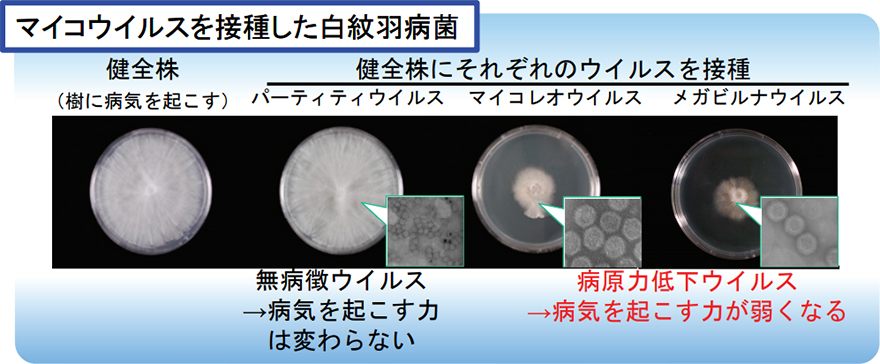

若手農林水産研究者表彰
平成23年度(第7回)業績概要

受賞者:佐々木 厚子 氏 39歳
独立行政法人農業・食品産業技術総合研究機構 果樹研究所 主任研究員
略歴
平成11年東北大学大学院農学研究科修了。農林水産省 果樹研究所 特別研究員、日本学術振興会 特別研究員、果樹研究所 任期付研究員等を経て、平成23年より現職。農学博士。
業績概要
主な業績
果樹類白紋羽病は白紋羽病菌(植物の糸状菌病)によって引き起こされる病害で、果樹の根部に感染して腐敗させ、最終的に枯死させてしまう。本病防除は多量の農薬(50?200リットル)を土中に潅注して行うが、完全な防除は困難で数年おきに潅注を繰り返す必要がある。これに替わる新たな防除法として、白紋羽病菌にマイコウイルス(糸状菌に感染するウイルス)を感染させ、病気を起こす力(病原力)を弱めて防除を行う目的で以下の成果を上げた。
白紋羽病菌に感染していたマイコウイウルス(パーティティウイルス)の純化粒子の観察およびシークエンス解析を行ってウイルス種を明らかにした。
純化したマイコウイルス したマイコウイルス(パ ティティウイルス ーティティウイルス、マイコレオウイルス マイコレオウイルス、メガビルナウイルス)の粒子を白紋羽病菌に接種する方法を確立した。
マイコウイルスの接種法を確立したことから、特定のウイルスが感染していない健全な白紋羽病菌に3種のマイコウイルスを感染させて、パーティティウイルスは感染しても影響がない無病徴ウイルスであり、マイコレオウイルスとメガビルナウイルスは白紋羽病菌の病原力を低下するウイルスであることを明らかにした。
白紋羽病菌で見つかったマイコウイルスは、リンゴ腐らん病等他の植物病原糸状菌にも白紋羽病菌と同様の手法で感染させることが可能であった。
背景
果樹類白紋羽病では、農薬に変わる環境に優しく安全な防除手法が求められている。
研究内容・成果

マイコウイルスを利用した糸状菌病害防除の実用化を目指して
ポットレベルでのマイコウイルスの伝搬試験
媒介生物等を利用した圃場での簡易なウイルス感染法の探索
圃場内でのマイコウイルスの消長の追跡
主要論文・特許
?「Artificial infection of Rosellinia necatrix with purified viral particles of a member of Mycoreovirus reveals its uneven distribution in single colonies」Phytopathology 第97巻第3号(2007)
?「Infection of Rosellinia necatrix with purified viral particles of a member of P i i i id (R PV1 W8)」A hi f Vi l 第151巻第4号 (2006)
? 特許第3692395号「ベクターモノカリオンを用いた紫紋羽病菌に対する新規なdsRNA導入法装置」(2005)
本研究業績は、ナシやリンゴ等の白紋羽病菌の病原力の低下に有効なマイコウイルスを発見するとともに、白紋羽病菌に接種し病原力を低下させる技術を開発した。マイコウイルスによる防除は減農薬の視点からも期待できる点が高く評価された。
連絡先
独立行政法人農業・食品産業技術総合研究機構 果樹研究所
〒305-8605 茨城県つくば市藤本2-1
TEL 029-838-6454
お問合せ先
農林水産技術会議事務局研究調整課
代表:03-3502-8111(内線5810)
ダイヤルイン:03-3502-7399
FAX番号:03-5511-8622




